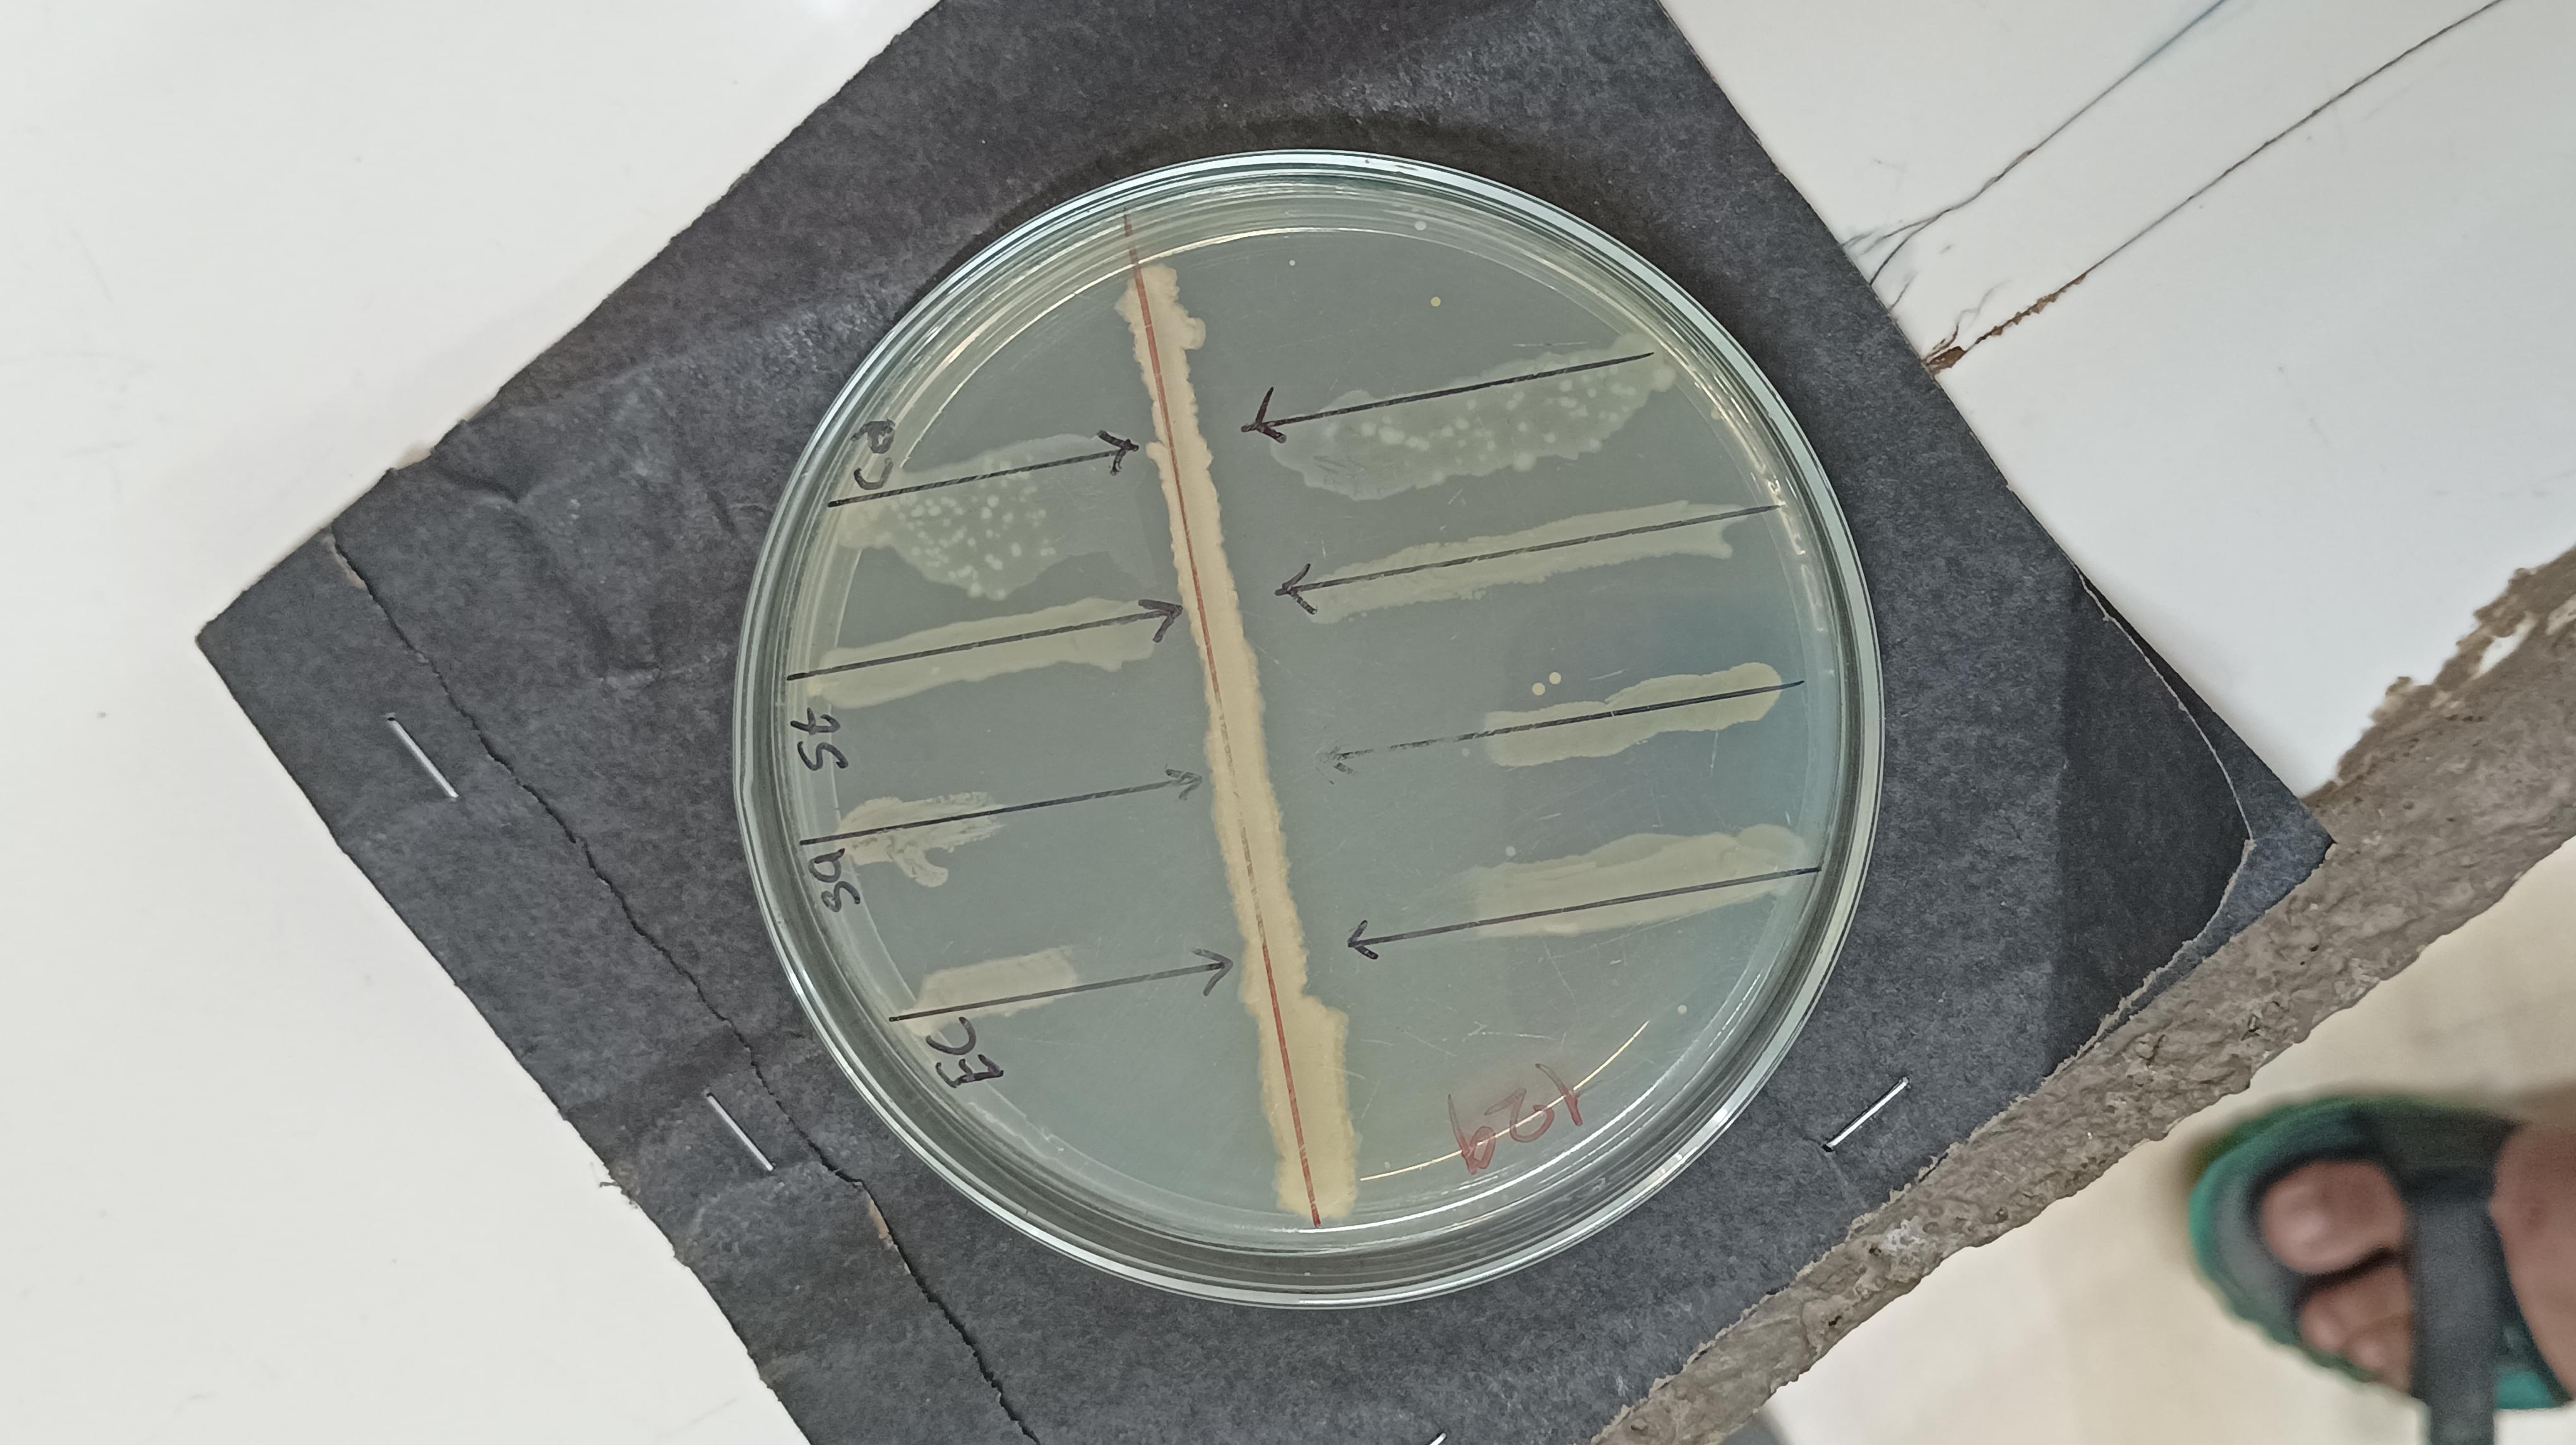

Chandibai Himathmal Mansukhani College (CHM), Thane, is an autonomous college established in 1965. BSc and BCom are the most popular programs at DDCE.
- Recognition: CHM is recognised by UGC and accredited B by NAAC.
- Courses Offered: CHM offers UG and PG courses.
- Fees: The first-year fee for the B.Sc. Fees is INR 29,318.
- Admission Criteria: For the PhD course, candidates need a Post-graduation degree from a UGC recognised Board and must have attempted the PET exam.
- Admission to the UG & PG courses is done on a Merit basis to only those candidates who have passed 10+2 from a recognised Board.

CHM Courses & Fees 2025
CHM offers various courses in UG and PG Courses in multiple specialisations. The Popular course that they offer is BSc in over 9 specialisations. Courses like BA, BCom and BMM are also available at CHM.
CHM UG Courses & Fees 2025
CHM offers a BSc in 9 disciplines and BCom course in 4 specialisations. Here are the details of all the courses along with their fees, eligibility and selection criteria in a tabulated form:
| Courses | Eligibility | Selection | First Year Fees |
|---|---|---|---|
| B.Sc (CSE) | 10+2 | Merit | INR 29,318 |
| B.Com | 10+2 | Merit | INR 17,968 |
| BMS | 10+2 | Merit | INR 17,668 |
| B.M.M | 10+2 | Merit | INR 17,668 |
| BA | 10+2 | Merit | INR 6068 |
CHM PG Courses & Fees
CHM offers admission to various PG courses across different specialisations. For admissions into PG courses, candidates need to have a Bachelor's degree in that particular subject. Here are the admission details for the major PG courses at CHM.
CHM PhD Admissions 2025
CHM offers PhD admissions to only those candidates who have completed Post-graduation from a UGC recognised University with a minimum of 55% along with an attempt in the PET Exam. Here are the eligibility and selection criteria for all the major specialisations of the PhD in a tabulated form:
| Courses | Eligibility | Selection | First Year Fees (INR) |
|---|---|---|---|
| PhD | Postgraduation | PET Exam | INR 7365- INR 20365 |
CHM Admission Process 2025
CHM offers admissions to UG and PG programs to all the eligible candidates. For UG and PG Courses, Candidates need to pass their 10+2 from a recognised board. Admissions to both courses are done on the basis of merit. For the PhD course, candidates need a Post-graduation degree from a UGC recognised Board and must have attempted the PET exam. The Admission process is mentioned below.
- The Admission Procedure for filling of college admission form and payment of fees is available online on the college website.
- Students can fill up the Application form in Online mode only.
- Once the form is submitted by the students, the college will verify the students’ information, and only then can the students make the payment online.
- The Notification for approval of admission and payment of fees will be sent to the students via Email. Before filling up the admission form, the First students should have a Pre-Enrolment Application Number (mentioned on the top right-hand side of the Pre-Enrolment form filled).
Note: While making payment, ensure that the phone number and email id mentioned is he same as mentioned on the college admission form otherwise, payment will not be accepted, and students will not be confirmed for their admission for the said courses. The other board student, i.e. student who has passed XIIth or equivalent exam from other than Maharashtra State, shall obtain a Prima facie certificate from the University of Mumbai.

CHM Documents Required 2025
The documents required for admission to CHM are:
- Printed Admission Form
- Pre-Enrolment Form
- Two copies of the HSC Marksheet
- One copy of Xth Marksheet
- One copy of Leaving Certificate
- One copy of Aadhaar Card
- Anti-Ragging Form signed by Parents
- Address Proof
- Caste Certificate
- One passport-sized photograph
CHM Scholarships 2025
CHM provides Scholarships to Needy and Meritorious students. All financially needy students of the college who meet the following eligibility criteria can apply by filling out the form and submitting it to the college's administrative office.
| Name of the Scholarship | Eligibility Criteria |
|---|---|
| Kishinchand Chilaram Educational Scholarship Assistance Program for needy students | Candidates must have scored 60% aggregate in the Previous year's Examination from a recognised board/ University. The Family Income of the applicant should be more than 3 lakhs per annum. The other things being equal, participation in extracurricular curricula may be given weight. |
| Geeta Israni Scholarship | Marks scored by the applicant, in the previous examination, should be a minimum 60% from a recognised board/ University. Students should score a minimum 60% marks in the final examination of each subsequent year to be eligible for continuation of the scholarship. The Family Income should not exceed 3 Lakh |
| Indusind Foundation Trust Scholarship | Marks scored by the applicant in the previous examination should be a minimum 70% . The Family Income should not exceed 3 lakh |
| Late Padma & Naniksingh Mansukhani | a) Any Needy-Sindhi Girl Student |
| Late Naniksingh Hoondomal Mansukhani | a) Any Needy-Sindhi Girl Student |
| Late Miss Devi Hoonomal Mansukhani | a) Any Needy-Sindhi Girl Student |
CHM Placements 2025
CHM Placement 2025 report has been released. However, as per the latest NIRF overall report available on the official website, the median package offered was INR 27.81 LPA to a 3-year UG program, and the Median Package offered was INR 0 LPA to a 2-year PG program.
CHM Placement Highlight 2025
Here are the important placement highlights of CHM.
| Particular | Statistics |
|---|---|
| Total Students | 6099 |
| Number of Students Placed | 3 |
| Median Package (3-year UG) | INR 27.81 LPA |
CHM Campus Infrastructure & Facilities 2025
CHM provides a lot of facilities for the students by building a technology-friendly environment in various locations on the campus. The provided facilities are:
- Auditorium: The auditorium is useful for conducting college meetings, co-curricular and extra-curricular activities at the National and International levels. It is air-conditioned and well-equipped with a high-definition LCD projector and sound system.
- Seminar Hall: The College has a well-equipped, air-conditioned Seminar Hall for conducting seminars, workshops, Intra and Inter-Collegiate events, visiting lectures and tutorials at the college level by various Departments, Associations, Forums, Committees and Faculties, etc
- Laboratories: The College has spacious and well-equipped 15 laboratories in the subjects of Chemistry, Physics, Botany, Zoology and Microbiology, Computer Science and I.T. for the Junior and Degree college. The Chemistry department has a spacious post-graduate laboratory and a research Laboratory, the Microbiology department has two research laboratories, and the Botany, Physics and Zoology department has one research laboratory each
- Gymkhana: Gymnasium has an area of 900 sq. ft. under the UGC Grant Scheme. The Gymkhana committee manages the activities and maintenance of Gymkhana. The committee regulates the Gymnasium timings. The best student of sports is inducted as the Gymkhana Student Secretary.
- Language Lab: The Language Lab will provide special coaching in English, Marathi, Hindi and Sindhi language teaching and will seek to improve the spoken and written communication skills of our students. Besides this, a Media room has been established for B.M.M. students.
- Botanical Garden: The College has a well-developed Botanical Garden. The College has also developed a Medicinal Garden & Plant Conservatory.
- Canteen: The canteen is attached to the main building, and it runs under the supervision of the college administration through the canteen committee.
- Library: The library of CHM College, the fountain of knowledge and inspiration, enjoys the reputation of being one of the premier college libraries in the vicinity. The library was established in 1965 with the inception of the college.
- Parking Facilities: Huge parking spaces for vehicles of Staff and Students is also available at their own risk.

Cafeteria

Classrooms

Indoor Games Area

Library

Main Entrance

Main Building

Playground

Open Auditorium
Conclusion
- The Exceptional Faculties and vibrant community on the campus make its admission more purposeful.
- CHM not just believes in handing over a degree but also works in transforming every individual into a better citizen of tomorrow.
- CHM takes the responsibility of reshaping every student’s career.
- Laboratories and wide open grounds give a sense of belonging to all its students, giving a sense of a second home.
CHM FAQs
Ques. What do students do in the Reading Room in CHM?
Ans. The reading room is attached to the Library's main building as well as in the extension building. Students have free access to the Magazines and the Newspapers. Internet facility is provided on 12 computers 5 for OPAC and 7 in the internet resource centre. This helps the students to get the required information on their subject of interest. To inculcate reading habits in users, CHM undertakes “Touch the Untouched”, A book exhibition of our own collection. CHM displays untouched books to make users aware of the collection and also to spread awareness of important days. Students can place their hands on the books related to the theme of that day. This is a continuous activity in the library to develop, and that is why students have named it the Reading Room.
Ques. What are the Eligibility Criteria for BSC admission in IT in CHM?
Ans. A Candidate for being eligible for admission to the degree course of Bachelor of Science Information Technology, shall have passed XII standard examination of the Maharashtra Board of Higher Secondary Education or its equivalent with Mathematics and Statistics as one of the subjects OR Candidate who have passed Diploma (Three years after S.S.C. or XII Std.) in Information Technology / Computer Technology / Computer Engineering / Computer Science / Electrical, Electronics and Video Engineering and Allied Branches / Mechanical and Allied Branches / Civil & Allied branches are eligible for direct admission to the Second Year of the B.Sc. (I.T.) degree course. However, the diploma should be recognised by the Board of Technical Education or any other recognised Government Body.
Ques. How are the basic facilities in CHM?
Ans. The curriculum is fantastic, and it prepares students for the industry and provides a good future for them. Some curriculums are outdated, but the teaching staff is experienced and well-behaved. The college is good for studies. Having good infrastructure and learning facilities like cs labs. CHM also has good courses for future development and personality development. CHM has affordable fees for all courses and a big campus as well. CHM college has a big campus compared to other colleges, and the college organises many events like chandi utsav and sports events like cricket, handball, and many other games and campus has good infrastructure, having big trees and a vehicle parking area for students and having place for studies for the students.

![Smt. Chandibai Himathmal Mansukhani College - [CHM]](https://image-static.collegedunia.com/public/college_data/images/logos/1764656580chmlogo.png?h=71.7&w=71.7&mode=stretch)

.jpg?h=42.55&w=42.98&mode=stretch)




![St Wilfred’s College of Arts, Commerce & Science- [SWCACS]](https://image-static.collegedunia.com/public/college_data/images/appImage/1731740203images1.jpg?h=111.44&w=263&mode=stretch)


























![Ramniranjan Jhunjhunwala College - [R.J.C]](https://image-static.collegedunia.com/public/college_data/images/logos/1515241499logonew12.png?h=72&w=72&mode=stretch)


.jpg?h=72&w=72&mode=stretch)


Comments
Found 11 Comments
CHM courses are offered at UG, PG, Doctorate level. There are 45 courses offered at CHM. The courses are offered in fields like Commerce, Science, Management, Arts. CHM courses includes B.Sc, B.Com, BA, BMS, M.Com, M.Sc, MA, Ph.D, B.M.M. The popular courses at CHM is B.Sc, B.Com, BA.
Smt. Chandibai Himathmal Mansukhani College (CHM College) in Ulhasnagar, Thane, offers the Bachelor of Commerce in Accounting and Finance (B.Com. A&F) program, commonly referred to as the BAF course. This is a three-year full-time undergraduate program affiliated with the University of Mumbai.
CHM offers 45 courses at the undergraduate, PG, and doctoral levels on its campus. The courses are offered in fields like Commerce, Science, and Arts. Some of the most popular CHM courses are B.Sc, B.Com, BA.
CHM Fees for popular courses are mentioned below.
Smt. Chandibai Himathmal Mansukhani College (CHM College) in Ulhasnagar, Thane, offers a Bachelor of Science (B.Sc.) in Psychology. The annual tuition fee for this course is approximately INR 16,000, totaling around INR 48,000 for the entire program. Applicants must have completed their 10+2 (HSC) education from a recognized board with a minimum of 45% aggregate marks
The admisisons have already been concluded for the academic session 2024-25. MAH BBA/BCA CET 2025 Exam Date has been announced by the Maharashtra State CET Cell for admission to BBA/ BCA/ BBM/ BMS Courses for the academic session 2025-26. MAH BBA/ BCA CET 2025 will be conducted tentatively on April 1, 2 & 3, 2025
The total fee for the Bachelor of Pharmacy (B.Pharm) program at Smt. Chandibai Himathmal Mansukhani (CHM) College in Ulhasnagar is approximately ?1,02,400 for the full duration of the course. This fee includes various charges such as tuition, library, and examination fees.
The first-year fee is INR 29,033, the 2nd-year fee is INR 30,463, and the 3rd-year fee is INR 32,713 at the Smt. Chandibai Himathmal Mansukhani College. Aspirants seeking admission to 3 year Full-time B.Sc Program should have passed XII Std. Examination Maharashtra Board of Higher Secondary Education or its equivalent with Mathematics and Statistics as one of the Subject.
The per year fee of CHM Thane PhD is INR 7,280.
To get admission to MA English, you need to have passed BA from a relevant discipline to be eligible.
The Smt. Chandibai Himathmal Mansukhani College does not offer LLB course.
The course details of CHM Thane M.Com. are mentioned below: